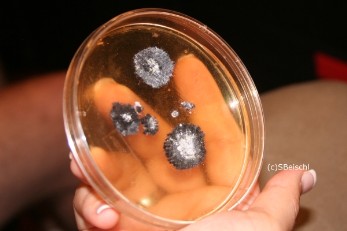

TV Moments
Hauptmenü
Evidence
DougStuff
Jenny Shepards Kleidung, in der sie erschossen wurde (5.18):




Die Kugel, mit der Kate von Ari Haswari (laut Beweis-Datum am 22.09.2004) erschossen wurde (2.23):

Halsband von Schäferhund "Jethro" (5.13):






Fußabdrücke (4.15):



Hotel-Schlüsselkarten (teilweise 5.18/19):


Cookies und Tarot-Karte (5.14):






